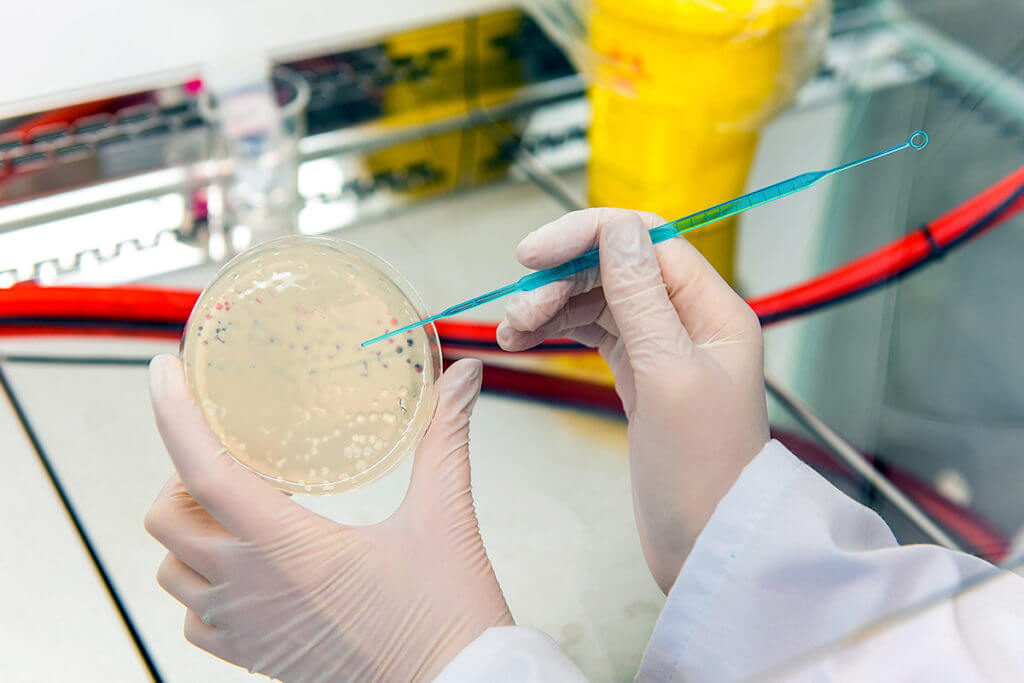
Come vengono prodotti i fagi?

Batteriofagi
I fagi stanno diventando sempre più importanti nella medicina moderna. Dopo essere stata quasi dimenticata a causa degli antibiotici, attualmente sta vivendo un ritorno.
Ciò è dovuto anche al costante aumento di germi multiresistenti. I batteriofagi rappresentano un approccio terapeutico delicato nell’Europa orientale, in quanto hanno un effetto autoregolatore senza lasciare tracce o effetti collaterali.
La terapia con i fagi è interessante per le persone per le quali il classico approccio farmacologico non è più utile. L’uso medico non è autorizzato nell’UE, tranne che in Belgio. In caso di malattie della pelle o per rafforzare la flora cutanea i batteriofagi possono essere utilizzati esternamente.
Tuttavia, i trattamenti con batteriofagi sono attualmente in corso solo in Georgia, Russia e Ucraina.
Puoi scoprire come funziona, cosa sono esattamente i batteriofagi, come funzionano e come vengono utilizzati nella pagina seguente.


Cosa sono esattamente i batteriofagi?
Tradotto dal greco, batteriofagi significa“mangiatori di batteri“. Questo nome non è una coincidenza.
I fagi sono virus specializzati nella distruzione delle cellule batteriche. I batteriofagi, come vengono chiamati in inglese, infettano i batteri maligni prima di moltiplicarsi al loro interno.
Tuttavia, il processo è molto più complicato di quanto questa breve descrizione possa far pensare.
In linea di principio, i batteriofagi, o semplicemente fagi, vengono utilizzati ovunque si trovi il batterio giusto. Infettano solo i ceppi all’interno di una specie batterica senza superare i confini di specie.
Proprio come i batteri, i batteriofagi sono soggetti a una costante evoluzione e continuano a svilupparsi insieme a loro.
Questo significa che sono sempre un passo avanti rispetto ai batteri e rimangono efficaci. Al contrario, i batteri stanno diventando sempre più resistenti agli antibiotici.
Con l’aumento dei germi multiresistenti in medicina, anche i fagi stanno giocando un ruolo sempre più importante.
Sebbene non siano noti effetti collaterali degni di nota, alcuni fagi penetrano nei biofilm meglio degli antibiotici prodotti in farmacia.
La storia dei fagi
Félix Hubert d’Hérelle, biologo e microbiologo canadese nato a Parigi, è generalmente riconosciuto come lo scopritore dei batteriofagi.
È stato anche colui che ha dato ai cosiddetti “mangiatori di batteri” il loro nome, che viene usato ancora oggi. Già nel 1919 trattò per la prima volta con successo un paziente con batteriofagi.
Oggi la Georgia è uno dei pionieri della tecnologia dei fagi con l’Istituto Georgi-Eliava.
L’istituto prende il nome da Georgi Eliava. Mantenne uno stretto contatto con d’Hérelle e fondò la struttura di ricerca come laboratorio batteriologico nel 1923.
Negli Stati Uniti, l’azienda Eli Lilly era già presente sul mercato negli anni ’40 con sette diversi prodotti fagici da utilizzare nell’uomo.
Tuttavia, i primi antibiotici furono disponibili in Europa e negli Stati Uniti nello stesso periodo. Di conseguenza, la terapia con i fagi è diventata rapidamente poco attraente.
Solo ora la situazione sta gradualmente cambiando. L’arsenale degli antibiotici non ha quasi nessuna novità e sempre più batteri sono resistenti ai principi attivi esistenti.
La ricerca non si ferma e nuovi farmaci e terapie sempre più efficaci vengono immessi sul mercato.
Allo stesso tempo, però, molti batteri stanno diventando sempre più resistenti. I germi multiresistenti sono spesso conosciuti come“germi ospedalieri” e possono avere conseguenze fatali per la salute del paziente.


Come sono strutturati i fagi?
I fagi si differenziano in base alla struttura del loro genoma e vengono classificati in diversi gruppi.
Anche se possono differire notevolmente per forma e dimensioni, sono simili nel loro sviluppo attraverso la riproduzione. Non avendo un proprio metabolismo per riprodursi, hanno bisogno di una cellula batterica viva e adatta come ospite.
La riproduzione è più o meno la stessa per tutte le forme. Inizia con l’attacco dei batteriofagi alla superficie batterica. Il fago introduce il suo materiale genetico nel batterio.
La produzione di nuovi fagi inizia ora all’interno del batterio. Non appena la produzione dei nuovi batteriofagi è completa, l’involucro del batterio si dissolve (lisi) e viene così distrutto. I fagi non sviluppati rilasciati iniziano un nuovo processo.
Quali batteriofagi sono differenziati?
Come già detto, esistono diversi gruppi o famiglie di fagi. Sono classificate tassonomicamente in base alla loro morfologia, al loro genoma e al loro ospite.
Si distingue tra fagi a DNA a singolo filamento, i cosiddetti fagi ssDNA (a singolo filamento) e quelli a doppio filamento, i cosiddetti fagi dsDNA (a doppio filamento).
Attualmente si conoscono più di 6000 batteriofagi diversi. Ad esempio, ci sono i fagi temperati.

Batteriofago caudovirale
Le caudovirales sono probabilmente il gruppo più numeroso. Si riconoscono per la coda, lunga fino a 230 nm, che pende dalla testa icosaedrica.
Il genoma lineare a doppio filamento di DNA si trova nella testa. All’interno delle Caudovirales si possono classificare diverse famiglie di fagi, che seguono vie di infezione leggermente diverse nei batteri.
Diversi di una serie di fagi disponibili possono rivelarsi adatti a un patogeno batterico.
In termini di terapia con batteriofagi, l’obiettivo è quindi quello di utilizzare miscele di fagi diversi e sfruttarne l’effetto sinergico.
Allo stesso tempo, è possibile ridurre la resistenza dei fagi batterici.
La resistenza batterica dei batteriofagi è un aspetto importante. Tuttavia, nella scelta di una terapia adeguata con i fagi vengono prese in considerazione anche altre proprietà.
Come vengono prodotti i fagi?
I fagi sono costituiti da materiale genetico e da un mantello proteico. Di conseguenza, non possono riprodursi senza una cellula ospite.
Tuttavia, una volta trovata una cellula ospite adatta, la inducono a moltiplicare il materiale genetico del fago. Dopo il decadimento o lo scoppio del batterio, il materiale genetico viene rilasciato.
Sono considerate armi biologiche contro i batteri e un’efficace alternativa agli antibiotici. Poiché i batteriofagi possono essere utilizzati in molti modi diversi, attualmente vengono testati per verificarne l’efficacia in diversi studi clinici.
Ad esempio, un progetto di ricerca tedesco si è prefissato l’obiettivo di rendere i batteriofagi un farmaco autorizzato contro le infezioni batteriche o le malattie infettive.
Il progetto “Phage4Cure” è stato avviato dalla Charité di Berlino perché la resistenza agli antibiotici è in aumento in tutto il mondo. 1
A questo scopo, vengono allevati in laboratorio in base al rispettivo settore di applicazione. Vengono poi miscelati in un cocktail basato su una ricetta per la rispettiva applicazione.
Si distingue tra un approccio personalizzato e una formulazione fissa composta da diversi fagi.
Soprattutto negli ospedali, i germi multiresistenti o i germi ospedalieri (ad esempio Acinetobacter Baumannii o Pseudomonas Aeruginosa) spesso portano a complicazioni nei pazienti.

Dove vengono utilizzati i fagi?
In teoria, i fagi possono essere utilizzati per la terapia ovunque sia necessario uccidere i batteri. Nei paesi dell’Unione Europea, l’uso medicinale è attualmente consentito solo in Belgio. Qui vengono assunti per via orale o iniettata.
I fagi sono utilizzati principalmente per le malattie della pelle o per rafforzare la flora cutanea. I batteriofagi vengono applicati esternamente. I fagi presenti in natura sono concentrati sotto forma di spray.
In questo modo, il loro effetto può essere sfruttato per rafforzare l’equilibrio della flora cutanea.
Gli spray con batteriofagi concentrati sono attualmente disponibili per l’uso nelle seguenti malattie della pelle:
- Pelle soggetta a neurodermite
- Fagi per l’acne
- Pelle soggetta a rosacea
- Pelle sensibile a causa del diabete
Questo tipo di applicazione di fagi è un modo naturale e delicato di affrontare le malattie dermatologiche croniche.
PROTEGGERE LA PELLE
Protezione probiotica della pelle SkinCare Protect con tecnologia Phage.
La tua pelle si riposa.
- Lenisce immediatamente il prurito
- Riduce gli arrossamenti e previene le infiammazioni
- favorisce l’equilibrio della flora cutanea
- pH neutro, senza alcool, senza cortisone e sterile – dermatologicamente testato
Documentario di conoscenza sul tema della terapia con i fagi
Questo documentario della Bayerischer Rundfunk mostra come i fagi possano aiutare a combattere le malattie. Tonja soffre di fibrosi cistica, una malattia ereditaria in cui la funzione metabolica è difettosa.
La donna è anche affetta da un germe multiresistente nei polmoni. Ciò significa che nessun antibiotico può aiutarla a combattere questo germe.
L’ultima risorsa per Tonja prima del trapianto di polmone è la terapia fagica. Tuttavia, questo non è autorizzato nell’UE.
- 1.Dr Rohde C, Prof Dr Witzenrath M, Dr Hüser A. I batteriofagi come farmaci nella lotta contro le infezioni. Fraunhofer ITEM. Accesso al 6 aprile 2021. https://www.item.fraunhofer.de/de/leuchtturm-projekte/bakteriophagen.html

